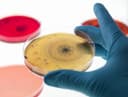
Thumbnail 5

🔬 Unleash Curiosity with Every Petri Dish!
The Bacteria Science Kit is a comprehensive educational tool designed for kids aged 9 and above, featuring 10 pre-poured agar plates, sterile cotton swabs, plastic droppers, and a detailed project guide. This kit prioritizes safety and convenience, making it perfect for budding scientists eager to explore microbiology and excel in science fairs.







| ASIN | B081VCRWQ4 |
| Age Range Description | Baby |
| Best Sellers Rank | #196,616 in Toys & Games ( See Top 100 in Toys & Games ) #1,979 in Educational Science Kits |
| Brand Name | Onnetila |
| Customer Reviews | 4.1 4.1 out of 5 stars (972) |
| Educational Objective | STEM |
| Is Assembly Required | No |
| Item Weight | 0.48 Kilograms |
| Manufacturer | Onnetila |
| Manufacturer Minimum Age (MONTHS) | 108.0 |
| Manufacturer Part Number | bacteria-2 |
| Material Type | Plastic |
| Model Number | bacteria-2 |
| Set Name | Set |
| Theme | Microbiology |
| UPC | 613617842477 613617842538 |
L**S
Great for discussing bacteria in class
I buy this kit every year for my kindle school class when we discuss cells. We cover a unit on bacteria so I let them go around campus and decide where to swab for samples. They get really grossed out when the bacteria start growing so well on the agar.
H**R
works great
Worked so great for our science fair project!
S**Y
Such a cool kit!
I did this as a child and won second place in the science fair at school. As I was telling my kiddo about the story, she was so intrigued, that I just had to order this and do it with her. She loves science so much and her mind was blown when things started to grow in the petri dishes. We swabbed the tv remote, her Nintendo and even her mouth! I was honestly shocked that the most growth came from a swab we took of her arm pit! Lol, gross, but bacteria is everywhere after all. Super fun but have patience as they’re growing. We kept ours in the garage inside of a closed box. It’s hot out there and dark, so it was perfect for bacterial growth. We also used hand sanitizer to see if it’ll kill any of the bacteria, and to our surprise, it didn’t do much. So, my consensus was that hand sanitizer doesn’t do much in the ways of killing bacteria, but all around, was very fun for me and my kiddo!
S**E
Experiment hindered
When I received this item, one of the Petrie dishes was completely busted and the part that busted out wasn’t included in the packaging. So it was busted before packaging. The gelatin solution got all of the other dishes. It was a mess! I had to throw out 2 of the dishes.
N**S
Dish Damaged
Good quality, but one of my dishes came broken :( Box was also damaged
C**C
Great for the classroom
I ordered these for my middle school kids. They were super easy to use. It's really nice that the agar is already in the dishes, and I didn't have to take the time to make that and then for it to set up. These are standard size petri dishes, they aren't small or novel in any way. I feel for the money, these are a win. The kit comes with everything but the gloves. For the money, this is way more affordable than some of the other big science education distributors. I will definitely order again.
A**A
Perfecto para jugar y aprender material de buena calidad
K**S
Not the best
If you’re not caring about the actual results, these are for you. The Petri dishes came wet and the agar melting. There were some dishes that were useable, maybe half, but had so much condensation and our results were not accurate. Unfortunately, a waste of money.
B**M
Teaching my 6 years old science atm and this was the perfect gift for her! It even comes with a little book! Still have plenty left, we can't wait to use them :)
M**S
Delivery on time and product is as per advertised.
L**N
Very interesting to see the bacteria grow. Don't keep them for too long though. I kept some of the gels for more than 2 months, and some white mold began to grow on the agar of the unused dished. Other than that, I think it is great experience for kids and adults alike as an educational hobby.
A**O
Works amazingly
ترست بايلوت
منذ شهر
منذ شهر